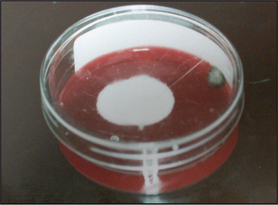
image

2 Laboratory tests
INTRODUCTION
Unless the diagnosis is immediately obvious, many dermatology cases in veterinary medicine present something of a challenge to the clinician. In these more complex cases, consideration of the signalment, history and physical examination allows formulation of a differential diagnosis, and then various tests and therapeutic trials are employed to reach a definitive diagnosis. The tests available include those performed within the practice laboratory and those offered by external commercial labs.
The ideal diagnostic test is a procedure that gives a rapid, convenient and inexpensive indication of whether a patient has or has not a certain disease. Unfortunately, most diagnostic tests suffer from a problem of inherent unreliability and cannot always distinguish the normal from the abnormal, leading to false-positive and false-negative results. Biological variation, test methodology and the skill of the clinician all combine to account for test unreliability. It is important the clinician is aware of the limits of any diagnostic test, and test results should be interpreted in the light of the case history and clinical signs. This interpretation is of crucial clinical importance and is one of the most common sources of diagnostic error.
There are measures that the clinician can take to minimize the incidence of false-positive and false-negative test results. Firstly, take full histories and perform full physical and dermatological examinations and draw up a differential diagnosis (see Chapter 1). Whilst it is important to perform basic screening tests such as skin scrapes and cytology, diagnostic tests used should as far as possible be targeted to the diseases on the differential diagnosis list. The indiscriminate use of a wide variety of diagnostic tests will increase the likelihood of false-positive and false-negative test results. It is a common mistake to assume that because skin lesions look severe, autoimmune disease is involved. Statistically, the low prevalence of rare diseases will increase the chance of a false-positive test result, leading to an erroneous diagnosis. Much more frequently, severe skin lesions are just an unusual manifestation of a common disease.
DIAGNOSTIC TESTS FOR ECTOPARASITISM
Ectoparasitic diseases encountered in small animal practice are shown in Table 2.1. The tests available for the detection of external parasites are combings and coat brushings, the use of acetate strips, skin scrapes, hair plucks, a scabies IgG ELISA test and histopathological examination.
Table 2.1 Ectoparasites encountered in small animal practice
| Insects | |
| Flea infestation | Common |
| Lice | Uncommon |
| Mites | |
| Sarcoptes scabiei | Common |
| Notoedres cati | Rare in cats |
| Cheyletiella spp. | Common |
| Otodectes cynotis | Common |
| Neotrombicula autumnalis | Common |
| Demodex spp. | Common |
| Endoparasites | |
| Pelodera, hookworms | Uncommon to rare |
General principles for microscopy
Become familiar with the operation of your microscope. Apart from when using acetate strips, always apply a coverslip over any material to be examined microscopically. Having excessive material on the slide will make thorough examination difficult. Low power (×4 objective) is sufficient magnification for detection of ectoparasites, although a ×10 objective may be required for more detailed examination of specimens.
Combings
A flea comb may be used to collect material from the coat for gross examination. The test is useful for the detection of larger external parasites such as fleas and lice. If fleas are present in large numbers, they should be seen. However, fleas are only detected in around 60% of cases of canine flea allergy dermatitis and the figure is considerably lower in cats, who remove evidence of flea infestation by grooming. Thus, flea combing is an insensitive test for the diagnosis of flea infestation.
Coat brushing examination
This is a useful and moderately sensitive test for the diagnosis of surface and superficial parasites such as fleas, lice, harvest mites and Cheyletiella spp. mites. Scale is dislodged from the dorsal trunk (Fig. 2.1) onto a piece of A4 paper by combing or vigorous brushing with the fingertips. The paper is folded and tapped so that the material collected falls into the crease. Hair is removed and the material can be examined grossly for the presence of flea faeces, as well as larger parasites such as lice. The material should be collected onto clear adhesive tape, mounted onto a glass slide and examined under the low-power light microscope. The complete area under the adhesive tape should be carefully examined.
Hair plucks
Microscopic examination of hair plucks may be useful to detect Demodex spp. mites (Fig. 2.2) and Cheyletiella spp. or louse eggs. Hair plucks are very useful when taking samples from areas that are difficult to scrape, such as the feet in the case of pododemodicosis, when skin scraping would require sedation. Fifty to 100 hairs are plucked and mounted in liquid paraffin on a glass slide under a coverslip. The hair tips, shafts and bulbs should all be carefully examined. One study showed deep skin scraping to be more sensitive than hair plucks in cases of localized and squamous demodicosis, and therefore demodicosis should not be ruled out on the basis of not finding mites on hair plucks.
Skin scrapings
Skin scrapings are used to detect the presence of superficial and deep parasitic mites such as Cheyletiella, Sarcoptes and Demodex spp. Skin scrapings should be performed when there is evidence of erythema, scaling, crusting, alopecia, or a papular or pustular eruption. In cases of canine scabies, the hocks, elbows and pinnal margins are prime sites for finding mites. Avoid scraping areas that are excessively crusted or excoriated, as this may lead to false-negative results. Three to five different sites should be sampled (five in the case of suspected scabies or demodicosis).
Hair should be clipped with a No. 40 clipper blade. When scraping for Demodex spp., it helps to gently squeeze the skin between thumb and forefinger, as this extrudes mites from the hair follicles. A small amount of liquid paraffin to suspend collected material (or water if using potassium hydroxide) is applied to the area to be scraped. A blunted No. 10 scalpel blade is used to scrape material from the skin surface. Deep skin scrapes resulting in capillary oozing should be made when looking for Sarcoptes or Demodex spp. mites (Fig. 2.3). Collected material is mounted onto a glass slide in liquid paraffin or potassium hydroxide. A coverslip should be applied. Examine samples for ectoparasites under the low-power objective and scan the entire area under the coverslip.
Canine Sarcoptes IgG ELISA
Commercial laboratories offer a Sarcoptes IgG ELISA test. This is a highly sensitive (∼90%) test, although false-negative reactions may occur in early cases because seroconversion may take up to 4 weeks following mite exposure. False-positive reactions may be seen in cases of canine atopic dermatitis due to house dust mite hypersensitivity because of cross-reaction between Dermatophagoides spp. house dust mites and Sarcoptes scabiei.
Histopathological examination
Histopathological examination is a very sensitive test for the diagnosis of demodicosis and if skin scrapes have been unrewarding, but demodicosis is still suspected, then histopathology would be the definitive rule out. Histopathologically, canine demodicosis results in interface mural folliculitis, perifolliculitis, folliculitis and furunculosis, and nodular dermatitis. Mites should be evident on histopathological sections. Histopathology is a highly insensitive test for other ectoparasitic diseases.
Interpretation of test results
With the exception of demodicosis, tests for ectoparasites are of low sensitivity but 100% specificity. Sarcoptes spp. mites are only found on skin scrape examination in around 50% of cases of canine scabies and Cheyletiella spp. mites may also be difficult to detect in some cases. Indeed, in multi-animal households, it can be helpful to check in contact (and frequently unaffected) animals for the presence of the parasite. Fleas are notoriously difficult to find, particularly in cats with any of the feline manifestations of pruritus.
Thus, other diagnostic tests (scabies IgG ELISA) or trial therapy should be performed where ectoparasitism is one of the differentials but external parasites cannot be detected.
Demodicosis
The situation is different in the case of demodicosis. Provided at least five carefully taken and thoroughly examined deep skin scrapes are negative, then the clinician can be confident in ruling out demodicosis as a cause of the skin disease, although there are rare exceptions. Possibly due to the thickness of their skin, it can be difficult to detect mites in the Shar Pei and occasionally mites can be difficult to find in cases of pododemodicosis. With such cases, histopathological examination is indicated to rule the disease in or out. Trial therapy is inappropriate for suspected demodicosis.
DIAGNOSTIC TESTS FOR DERMATOPHYTOSIS
Dermatophytosis is invasion of keratinized tissue usually by Trichophyton, Epidermophyton or Microsporum spp. of fungi.
Techniques available for diagnosis include:
Wood’s lamp: Wood’s lamp is an ultraviolet light with a wavelength of 360 nm. Only lamps with two bulbs and a magnifier should be used. It is important to switch the lamp on and allow it to warm up for 5 minutes prior to examination. Examination of the animal should be conducted in a darkened room. Hair shafts infected with certain strains of Microsporum canis fluoresce an apple green colour under Wood’s lamp examination due to tryptophan metabolites. Wood’s lamp examination is a test with high specificity (100% in the right hands) but low sensitivity, as only 50% of strains of Microsporum canis fluoresce. Rare infections with M. audounii, M. distortum and Trichophyton schoenlenii may also result in fluorescence.
Direct microscopy: Most dermatophytosis cases in domestic animals involve ectothrix invasion of hair shafts by fungal spores which can be visualized under ×40 magnification using the light microscope. Fluorescing hairs or hairs from lesions may be plucked for direct microscopic examination. Samples should be mounted on the slide in liquid paraffin or potassium hydroxide. Hair shafts with distorted or damaged cuticles should be examined under higher power for the presence of fungal spores (Fig. 2.4). Although a test with high specificity in the right hands, this is not a sensitive technique for the diagnosis of dermatophytosis in the hands of the inexperienced clinician.
Fungal culture: Fungal culture is arguably the most sensitive test for dermatophytosis and should be performed whenever this disease is suspected. The simplest method of collection of material for culture is the MacKenzie brush technique. This is most commonly used for routine screening of cats for dermatophytosis. A new toothbrush is used and hair and scale are collected on the bristles by brushing the hair coat for 30–60 seconds, paying particular attention to lesional skin. The shaft of the brush can be cut off and the entire head of the brush submitted to the laboratory. In addition to using the brush method, it is advisable to culture scale scraped from lesions and also hair plucks from lesion margins.
Dermatophyte test medium (DTM) is used as an in-practice growth medium for the diagnosis of dermatophytosis. DTM is Sabouraud’s dextrose agar with various antimicrobials that suppress bacterial and some saprophytic fungal growth, along with phenol red as an indicator. Dermatophytes metabolize protein in the medium first, giving off alkaline metabolites which turn the pH indicator red (Fig. 2.5). This should happen within 10 days and should occur as the fungal colony grows. Saprophytic species of fungi metabolize carbohydrates first and the red colour change should only appear after 10 or more days and subsequent to colony growth. There are potential problems associated with the use of DTM. The agar should be inspected daily for evidence of fungal growth and colour change; some saprophytic species of fungi can induce a colour change within 10 days and Microsporum persicolor may produce a colour change after 10 days. Thus, the identity of any fungal mycelium should be confirmed by microscopic examination, which requires specialist knowledge. Furthermore, DTM may not be a suitable growth medium for the identification of some fungi that will only sporulate on Sabouraud’s dextrose agar. Nevertheless, DTM culture remains a useful in-practice tool for screening for dermatophytosis, but the clinician should be aware of the limitations.
Figure 2.5 Dermatophyte test medium showing red colour change and white colony growth on the surface at 10 days. Note the darkly pigmented growth of saprophytic fungal organism on the edge of the plate.
Histopathology: Fungal elements may be identified on histopathological sections and are more readily visualized with the use of special stains such as periodic acid schiff (PAS).
TRICHOGRAPHY
Trichography is the technique of microscopic examination of hair shafts. Apart from ectoparasite diagnosis, the microscopic examination of plucked hairs is also useful in the investigation of causes of alopecia in cats and dogs and in certain scaling disorders, particularly sebaceous adenitis.
Technique: Fifty to 100 hairs are plucked using a pair of haemostat forceps, the jaws of which are protected by drip tubing so as not to fracture the shafts. The hairs are mounted on a microscope slide in liquid paraffin under a coverslip. Hair tips, shafts and roots are examined under the low-power light microscope.
Interpretation: Normal hair tips taper to a fine point. Fractured hair shafts indicate self-trauma due to pruritus. This is a useful test in cases of feline symmetrical alopecia where it is not clear that the cause of the alopecia is due to self-trauma (Fig. 2.6).
Examination of hair bulbs: A club-shaped, well-pigmented bulb is characteristic of a hair in the anagen (growing) phase (Fig. 2.7). A thin, straight, non-pigmented, fully keratinized tapered root is characteristic of a telogen (resting) hair (Fig. 2.8). In general, both telogen and anagen hairs will be seen on trichography from healthy cats and dogs. Assessment of anagen-to-telogen ratios can be helpful in ascertaining the cause of alopecia, although care must be taken in interpreting these ratios. Breeds such as the chow-chow, samoyed, Pomeranian and husky retain large numbers of telogen hairs for a long period of time and are said to have ‘telogen-dominated hair cycles’. Conversely, breeds including the poodle and Bichon Frise have ‘anagen-dominated hair cycles’, where the hair continues to grow. These are breeds that require hair cuts. Despite this breed variation, the absence of anagen hair roots in a trichogram would be suggestive of a hair growth cycle disorder such as an endocrinopathy. The presence of anagen bulbs indicates active hair growth and would make a hair growth cycle disorder less likely to be the cause of alopecia; self-trauma or a folliculitis would be more likely in such cases.
Follicular casts: The presence of follicular casts (accumulations of keratosebaceous material around the hair shaft) indicates a follicular cornification disorder of the hair follicle (Fig. 2.9). This is most commonly seen in the scaly form of sebaceous adenitis as seen in the Japanese akita and English springer spaniel.
CYTOLOGY
Cytology is a fundamentally important technique in veterinary dermatology that can be employed quickly, easily and inexpensively in a practice situation. Cytology frequently yields useful information on a case, and enables a more precise diagnosis to be made so that an accurate prognosis can be given. It will greatly enhance the chances of therapeutic success.
Cytology is useful in the diagnosis of:
Cytological techniques
In general, aim to take samples from fully developed lesions but before secondary changes have occurred. The best samples are from intact pustules, below crust, the leading edge of ulcers, and non-ulcerated tumours.
Glass slide impressions: Impressions may be taken from any exudative lesion. The lid of a pustule should be carefully opened with a fine needle before taking four or five impressions directly onto the glass slide (Fig. 2.10). Move the slide slightly before each impression to avoid too thick a build up of material. Be gentle when taking direct impressions, otherwise cellular damage will render the cytology uninterpretable. Where a direct impression is not possible, material may be transferred from the lesion to the slide by the use of a cotton bud. Impressions of the underside of crust can be diagnostically valuable, particularly in cases of suspected pemphigus foliaceus.
Acetate strips: Dry, greasy or waxy lesions are sampled using tape strips. A piece of tape about 50% longer than a microscope slide is used. The middle of the tape is pressed onto the area to be sampled several times to collect surface cells and debris. Each end of the tape is attached to one end of a microscope slide, forming a loop, and stained. Wrapping the tape around both ends of the slide holds it firmly in position and facilitates microscopic examination under oil immersion.
Ear cytology: Cytological examination of an aural discharge should be a standard procedure when faced with otitis externa. The findings are invaluable when deciding on the treatment to use and monitoring response to therapy. Samples of cerumen or pus can be collected from the vertical ear canals using cotton buds. The swab should be gently rolled onto the slide. The same slide may be used for both ears.
Needle aspiration: Nodules or swellings can be sampled by fine-needle aspiration. Most animals will tolerate needle aspiration without any form of chemical restraint. The mass to be sampled should be sprayed with alcohol and held firmly to avoid movement. The needle, usually 21-gauge, is introduced into the lesion and moved backwards and forwards several times, redirecting the needle so that different areas of the lesion are sampled. If necessary, the needle can be attached to a 5-ml syringe and negative pressure applied while the needle is within the mass. The pressure should be released before withdrawing the needle.
The needle is withdrawn and quickly attached to a syringe containing a few millilitres of air. The contents of the needle are then expelled onto a clean slide, which is quickly and gently smeared using a second slide. Speed is of the essence to avoid the sample dehydrating. The sample should be air dried and stained with a rapid stain.
Staining
Diff Quik® or Rapi-Diff® are suitable stains for cutaneous cytology. Staining technique varies depending on the sample. For samples that air dry on the slide, such as pus, serum or blood, the slide is first air dried and then all three components of the rapid stain are used. Waxy or greasy samples such as ear cytology samples should be heat fixed by passing through a Bunsen burner flame several times and stained without using the first component of the stain, which is an alcohol fixative. Similarly, tape-strip samples for Malassezia dermatitis are stained in just the red and blue dyes. Use of the alcohol fixative dissolves the waxy and greasy material in which the yeast organisms are found. Apart from when looking at tape-strip samples, contrast and definition are greatly improved by the use of a coverslip, which can be mounted on a drop of immersion oil or DPX.
Cytological interpretation
Normal cytological features
It is important to be aware of the normal features so that abnormalities may be recognized. Most skin surface preparations contain cells from the surface layer of the epithelium, known as corneocytes (Fig. 2.11). Corneocytes are large, polygonal, translucent cells. Corneocytes frequently contain round or slightly oval, black or brown melanin granules (Fig. 2.11), which should not be confused with bacteria that always stain a blue colour under Diff Quik®. Numerous dark blue cigar-shaped structures that are now thought to be root sheath remnants from hair follicles are seen on preparations from haired skin (Fig. 2.11). Hair shafts are usually seen in skin surface preparations. Occasional microorganisms may also be detected on skin surface preparations. These include yeasts (Malassezia spp.), bacteria (cocci and rods) and sometimes, particularly from the feet, saprophytic, non-pathogenic fungal spores, which are usually segmented and stain a green to blue colour (Fig. 2.12). Stain precipitate is frequently seen and appears as a blue or purple crystalline deposit.
Cytology from inflammatory lesions
Inflammatory cell types: Neutrophils, eosinophils, macrophages and lymphocytes may be seen in preparations from inflamed skin. It is important to be able to recognize these cells and be aware of their significance. Some inflammatory cells may take on different appearances depending on the disease process and ageing changes.
Neutrophils: Neutrophils (Fig. 2.13) are the most common inflammatory cell type seen in preparations from inflamed skin. They are seen in association with bacterial infections but may also be present in sterile disease processes. The presence of phagocytosed bacteria confirms an active bacterial infection. The distinction between a septic and non-septic aetiology may be difficult in the absence of bacteria, but the presence of ‘toxic’ or ‘degenerate’ neutrophils with swollen pale nuclei is suggestive of infection. As neutrophils age the nuclei shrink, become hypersegmented and darker staining. These are known as pyknotic cells. Neutrophils may be damaged during slide preparation, resulting in purple-staining streaks of nuclear material across the slide.

Figure 2.13 Neutrophils. Left to right: non-toxic cell, toxic neutrophil, pyknotic neutrophil and nuclear stranding.
Eosinophils: Eosinophils are easily recognized by their distinct red to orange granules (Fig. 2.14). There is considerable variation in granular morphology. Eosinophils are usually associated with allergic or parasitic diseases. They may be seen in large numbers from impression smears of feline eosinophilic plaques or indolent ulcers and from canine eosinophilic furunculosis. Eosinophils are also frequently seen in cases of canine deep pyoderma.
Macrophages: Macrophages are large mononuclear cells about one and a half times the size of a neutrophil. The cytoplasm of an activated macrophage takes on a foamy appearance due to the accumulation of proteolytic enzymes (Fig. 2.15). Macrophages are seen in some chronic inflammatory processes, often in association with neutrophils in pyogranulomatous inflammation, but may also be seen within a few hours of the initiation of inflammatory change. Therefore, their presence does not necessarily denote chronicity. The presence of pyogranulomatous inflammation even without evidence of bacteria is often due to infection and is commonly seen in impressions from canine deep pyoderma lesions.
Lymphocytes and plasma cells: Lymphocytes (Fig. 2.16) are mononuclear cells and are slightly smaller than neutrophils. Plasma cells are B lymphocytes, which have started to manufacture immunoglobulins. Lymphocytes and plasma cells are seen in some longer-standing and immune-mediated lesions. Large numbers of atypical lymphocytes may be seen in impression smears of lymphoma.
Microorganisms
Bacteria: Bacteria are commonly found in cutaneous cytology preparations. An inflammatory infiltrate with the presence of phagocytosed bacteria denotes an active infection (Fig. 2.17). Thus, finding neutrophils with phagocytosed cocci from an intact pustule confirms a bacterial pyoderma. On occasion, large numbers of bacteria, frequently adherent to corneocytes, may be evident without a significant inflammatory infiltrate. This may be seen in cases of long-standing, poorly controlled atopic dermatitis and is known as bacterial overgrowth syndrome (Fig. 2.18).

Figure 2.18 Corneocytes with many adherent cocci (arrows) from a case of bacterial overgrowth syndrome.
Malassezia spp.: Malassezia spp., unipolar budding yeasts, usually stain a purple colour with Diff Quik® (Fig. 2.19). In some situations only the capsule of the yeast stains and these are known as ghost forms (Fig. 2.20). The significance of finding yeast organisms on a cytological preparation depends on several factors, including the anatomical site and the presence or absence of visible inflammation. Finding the occasional yeast organism from the feet (or ear canal) is consistent with normal skin. However, if the skin is inflamed or there is evidence of pruritus, and yeasts are seen in several fields, then antifungal treatment would be indicated.
Acantholytic keratinocytes
Pemphigus foliaceus (see Chapter 17) results in the formation of pustules which contain large numbers of non-toxic neutrophils and acantholytic keratinocytes (Fig. 2.21). Less commonly, the pustule may also contain eosinophils. Acantholytic keratinocytes are nucleated keratinocytes from the stratum spinosum which have become detached from the epidermis and have a distinctive rounded appearance. Note that acantholytic keratinocytes may also be seen in other pustular and inflammatory dermatoses, including pyoderma and dermatophytosis.
Ear cytology
Cytological examination of any aural discharge should be a standard procedure when faced with otitis externa. The findings are invaluable when deciding on the treatment to use and monitoring response to therapy.
One of the most common primary inflammatory causes of recurrent otitis externa is atopic dermatitis. Frequently, in the early stages of atopic dermatitis, the dog may be presented with otitis externa and cytology reveals the presence of large numbers of corneocytes but no evidence of infection.
Occasional Malassezia organisms may be found in normal ear canals. Large numbers of yeasts will be seen in cases of Malassezia otitis externa. Cocci and/or rods will be seen in bacterial otitis and it is not un-common to find a wide variety of microorganisms. If a rod infection is present, samples for bacterial culture and sensitivity testing should be taken prior to starting therapy. The presence of neutrophils and phagocytosed rods is very suggestive of infection with Pseudomonas aeruginosa.
BACTERIAL CULTURE AND SENSITIVITY TESTING
Canine and feline pyodermas are common presen-tations. In general, bacterial culture and sensitivity is not routinely performed in these cases because the antibacterial sensitivities of causal organisms are well known.
Culture and sensitivity testing are indicated where:
Technique: The best lesion to sample is an intact pustule, which is opened with a fine hypodermic needle and discharge is collected onto the tip of a bacterial swab. Prior to opening the pustule the area should be gently swabbed with surgical spirit to remove surface bacterial contaminants. If there are no intact lesions then a swab from the underside of a crust or any other exudative lesion may be used, although the results should be interpreted with caution and the organism isolated should correlate with the results of cytological examination.
In deep pyoderma, swabs may be inserted into draining sinus tracts or the lesion gently squeezed to exude pus, which is collected onto the swab. Deeper tissue samples may be harvested for culture using a biopsy punch or elliptical incision. Commonly, such material is submitted for both culture and histopathological examination. If mycobacterial infection is suspected, samples may be frozen and only submitted for culture if histopathological examination is suggested of mycobacteriosis.
HISTOPATHOLOGY
Histopathological examination of skin biopsies is indicated in the following situations:
Histopathological examination is of little value in the investigation of most cases of pruritus.
Technique: Six- or 8-mm biopsy punches are suitable for most circumstances, although scalpel excision is necessary for larger or fragile lesions or when looking for evidence of panniculitis when there is a require-ment to include the subcutis. Unless an area such as the pinna, footpad, lip or nasal planum is to be sampled, sedation and local anaesthesia are usually adequate. Local anaesthetic should not contain adrenaline, as this will cause vasoconstriction within the sample.
The biopsy punch should be considered a ‘circular scalpel blade’. The punch should be placed perpen-dicular to the skin surface and a downward and rotational movement should be exerted to make the incision. The punch should not be rotated in both directions because this can induce artefactual changes in the sample.
It is important to biopsy lesions that are going to contain representative pathology. Suitable lesions include papules, pustules, vesicles, nodules, erosions or ulcers. Crusts are also of diagnostic value, but there is usually little to be gained from taking biopsies of chronic lichenified or excoriated areas. As a general rule, try and sample lesions at different stages of development. Take skin samples from the centre of the area of alopecia, as well as any advancing margin when sampling areas of alopecia.
Ideally, the excised tissue should be orientated for the pathologist so that the tissue can be sectioned in the plane of the hair follicles. This is most easily achieved by drawing a black line with an indelible marker in the direction of hair growth and taking the biopsy sample such that the line drawn bisects the sample (Fig. 2.22).
Sample submission: Dermatohistopathology is a specialized area and it is advisable to submit samples to laboratories with expertise in this field. To obtain the most useful information from the histopathologist, submission forms should be fully completed, giving signalment and a full history, including a description of disease progression, presence of any systemic signs, details of any previous diagnostic tests and results, and response to previous treatment. Only with this information will the pathologist be able to perform clinico-pathological correlation.
Interpretation of the histopathology report: Histopathology reports are usually divided into several sections. The first section details how many tissue sections were examined and gives the histopathological description of the lesions found. The next section gives the morphological diagnosis. This is a description of the histopathological reaction pattern. If the histopathological changes are pathognomonic then a specific diagnosis may be given, but it is more likely that the pathologist will discuss the changes and attempt to correlate them with the history given by the clinician.


















